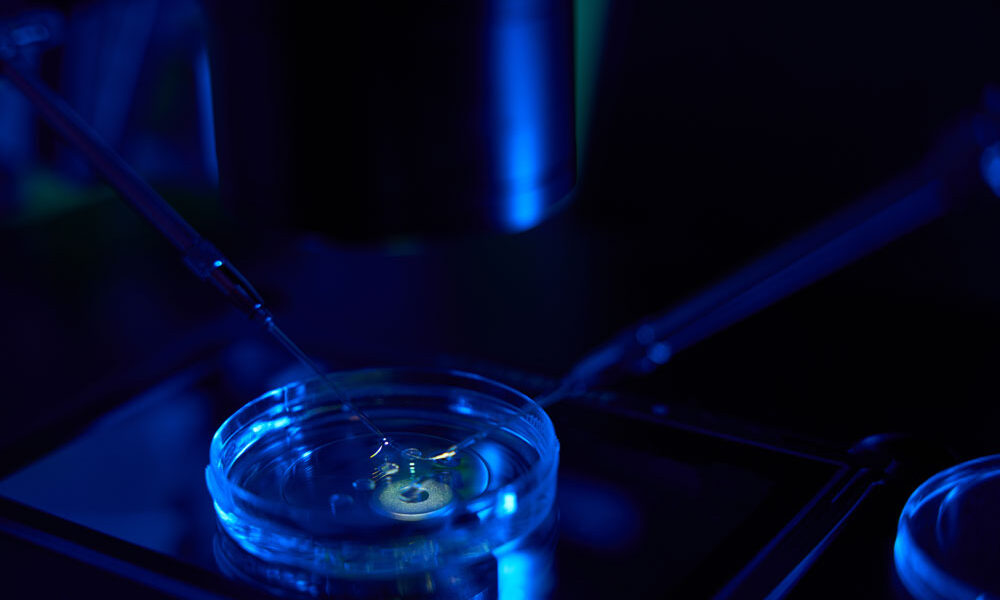
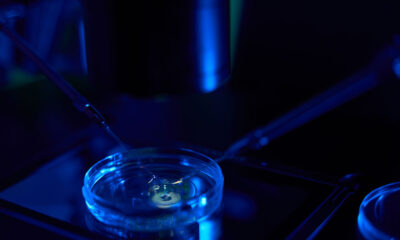

Renovatio 21 traduce questo contributo a firma di Louis Knuffke sul tema di morale e riproduzione artificiale apparso su LifeSiteNews. Quello che segue è un...



Renovatio 21 traduce questo articolo di Bioedge. La gametogenesi è un tema trattato in vari articoli di Renovatio 21. Sulla rivista Science Advances hanno descritto il processo: hanno...



La Conferenza Episcopale degli Stati Uniti d’America (USCCB) ha inviato una lettera al Senato degli Stati Uniti invitando i senatori ad opporsi e respingere il cosiddetto...



La rappresentante della Camera degli Stati Uniti Nancy Mace ha esercitato pressioni sui suoi colleghi repubblicani questa settimana affinché cosponsorizzino una risoluzione che condanna la sentenza...



Renovatio 21 traduce questo articolo di Bioedge. I politici si oppongono alla sentenza della Corte Suprema dell’Alabama secondo cui gli embrioni congelati IVF sono «bambini extrauterini». I medici affermano...



Renovatio 21 traduce questo articolo di Bioedge. È un vento cattivo che non porta bene a nessuno. Il calo dei tassi di fertilità in tutto il mondo preoccupa gli esperti...

Pochi giorni dopo che la Corte Suprema dell’Alabama ha riconosciuto gli embrioni umani congelati come bambini venerdì in un caso di fecondazione in vitro (IVF), le...



Malia Obama, figlia dell’ex presidente degli Stati Uniti Barack Obama, ha abbandonato il cognome del padre per il suo debutto a Hollywood. Malia Ann ha tranquillamente...



Renovatio 21 traduce questo articolo di Bioedge. Una decisione straordinaria della Corte Suprema dell’Alabama ha mandato i brividi in tutto il settore della fecondazione in vitro negli Stati Uniti. La...



La Corte Suprema dell’Alabama ha stabilito che gli embrioni congelati sono bambini ai sensi della legge statale e soggetti alla legislazione relativa alla morte ingiusta di...